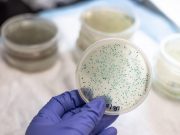
CDC Report Addresses Impact of COVID-19 on Antimicrobial Resistance

Tag: Infections: Misc.
CDC Report Addresses Impact of COVID-19 on Antimicrobial Resistance
Increases in resistant infections from 2019 to 2020 seen for carbapenem-resistant Acinetobacter, antifungal-resistant Candida auris
WHO Says Acute Hepatitis Cases in Children Now Reported in 11 Countries
Among 169 reported cases, at least one child has died; 17 children needed liver transplants
Guideline Issued for Preventing SSI After Major Extremity Trauma
AAOS developed 14 strong and moderate-strength recommendations to decrease surgical site infections after major extremity trauma
CDC Launches Forecasting Center for Infectious Diseases
Goal of the Center for Forecasting and Outbreak Analytics is to act as a 'National Weather Service' for infectious disease outbreaks
ACC: Infected CV Implantable Electronic Devices Often Not Removed
Although extraction within six days is linked to lower mortality, hardware not removed in 78.9 percent of patients with infected devices
Vaccination Offers Extra Protection After SARS-CoV-2 Infection
Two studies show additional protection against reinfection and COVID-19-linked hospitalization with vaccination
Risk, Burden of Diabetes Up After Acute SARS-CoV-2 Infection
Risks and burdens of postacute outcomes increased in graded manner based on COVID-19 severity
Nirsevimab Protects Against RSV in Late-Preterm, Term Infants
Single injection administered before RSV season protects from medically attended RSV-associated lower respiratory tract infection
Children, Adults Can Transmit SARS-CoV-2 to Household Contacts
Secondary infection risks were lower for primary cases aged 12 to 17 years compared with those aged 18 to 49 years
Signs/Symptoms May ID COVID-19 Even With Negative RT-PCR
Patients who repeatedly tested negative but had signs/symptoms of COVID-19 had similar seroprevalence as RT-PCR-confirmed cases